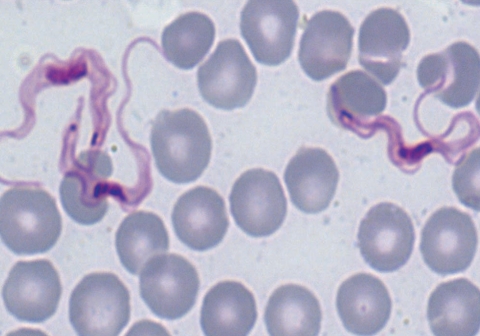
0

Abstract
Trypomastogotes of Trypanosoma brucei were detected from 4 asymptomatic kudus (Tragelaphus strepsiceros) on a game ranch located approximately 45 km north east of Lusaka, Zambia. Blood smears examined from 14 wildlife species comprising of the impala (Aepyceros melampus), Kafue lechwe (kobus leche kafuensis), sable antelope (Hippotragus niger), tsessebe (Damaliscus lunatus), warthog (Phacochoerus aethiopicus), puku (Kobus vardoni), zebra (Equus burchelli), waterbuck (Kobus ellipsiprymnus), bushbuck (Tragelaphus scriptus), reedbuck (Redunca arundinum), wilderbeest (Connochaetes taurinus), hartebeest (Alcephelus lichtensteini), African buffalo (Syncerus caffer), and kudu (Tragelaphus strepsiceros) showed that only the kudu had T. brucei. Although game ranching has emerged to be a successful ex-situ conservation strategy aimed at saving the declining wildlife population in the National Parks, our findings suggest that it has the potential of aiding the re-distribution of animal diseases. Hence, there is a need for augmenting wildlife conservation with disease control strategies aimed at reducing the risk of disease transmission between wildlife and domestic animals.
-
Key words: Trypanosoma brucei, game ranch, kudu, wildlife, Zambia
The rapid expansion of the game ranching industry as an exsitu conservation has significantly contributed to the expansion of the domestic wildlife interface areas in Southern Africa [
1,
2]. In Zambia, tsetse fly distribution is estimated to cover about 33% of the total landmass [
3,
4]. Hence, rearing of livestock in the tsetse infested areas calls for continuous prophylactic treatment impacting heavy management costs on the production of livestock. The shift in farming strategy from livestock rearing to game ranching is seen as an alternative which is swiftly replacing cattle ranching. Given the fact that most wildlife species are reservoirs of various diseases, including trypanosomiasis, the expansion of the wildlife industry in Southern Africa has the potential for disease re-distribution leading to the expansion of livestock and wildlife interface areas for disease transmission. In this paper, we report the detection of
Trypanosome brucei from greater kudus (
Tragelaphus strepsiceros) for the first time from wildlife on a game ranch discovered during routine surveillance. The role of wildlife in disease dispersion as a result of the expanding game ranching industry is herein highlighted.
The study was carried out on a game ranch in Chisamba located approximately 45 km north of Lusaka, Zambia. In October 2005, blood samples were collected from 14 wildlife species captured during a translocation exercise using M99 (etorphine hydrochloride) and reversed using M5050 revivon (diprenorphine) at standard capture dosages (Novartis SA Ltd, Animal Health, Johannesburg, South Africa). The buffaloes included in the study were immobilized for foot and mouth disease surveys, while 4 zebras (
Equus burchelli) and 4 kudus were sacrificed for feeding lions. The general body condition of the animals was good. The numbers of animals sampled on the ranch are shown in
Table 1. Thin blood smears were made from the ear vein on site. Second sets of blood smears were made from Buffy coats from blood collected in EDTA soon after arrival at the laboratory at the School of Veterinary Medicine in Lusaka. All the slides were examined after staining with Giemsa under a light microscope. The number of positive animals is shown in
Table 1, while
Fig. 1 displays the trypanosomes detected in a greater kudu. The length of the trypanosomes (= trypomastigote stage) averaged 28.7 µm (n = 100, SE = 2.3 µm). All trypanosomes observed showed presence of pronounced free flagella, a pointed posterior end and conspicuous undulating membranes as shown in
Fig. 1 and were identified as
T. brucei as described elsewhere [
5-
7].
In Zambia,
T. brucei has been reported from warthogs (
Phacochoerus aethiopicus), hyaena (
Crocuta crocuta), waterbuck (
Kobus ellipsiprymnus), lion (
Panthera leo), hippo (
Hippopotamus amphibius), and other wildlife species in the Luangwa valley [
8-
11]. The ecological habitat of the Luangwa valley supports the survival of wildlife reservoirs found in the North and South Luangwa National Parks. These animals provide a wide host range for vector tsetse flies [
3,
8,
9,
11]. However,
T. brucei has not been reported from wildlife on game ranches thus far.
As shown in
Table 1, only the kudu out of the 14 species examined showed presence of
T. brucei. In the absence of serological testing and screening using more robust diagnostic tools like PCR [
12], it is difficult to establish the prevalence of the disease on the game ranch. Considering that wild ungulates have been reported to asymptomatically maintain transient infections of trypanosomes for a long time in their blood [
13], it is likely that
T. brucei detected in kudus in the present study might have been present in these animals for a long time. It is not known whether these animals got the infection on the game ranch or they could have carried the infection from another source when they were brought on the game ranch. Given the fact that most of the animals sampled in the present study were for the purpose of translocation to other game ranches, these findings suggest that translocation of game animals to new habitats could serve as a disease dispersion mechanism. This is particularly true when disease carriers are translocated into ecological habitats that support co-existence of wildlife reservoirs and vector species. Hence, new ecological niches that support sylvatic cycles of wildlife diseases could easily be established outside the commonly known endemic areas. The findings obtained in the present study are particularly important in promoting active surveillance and designing effective disease control strategies aimed at preventing the transmission of wildlife diseases to domestic animals and humans.
References
- 1. Bengis RG, Kock RA, Fischer J. Infectious animal diseases: the wildlife/livestock interface. Rev Sci Tech 2002;21:53-65.
- 2. Mossman AS. International game ranching programs. J Anim Sci 1975;40:993-999.
- 3. Clarke JE. Trypanosome infection rates in the mouthparts of Zambian tsetse flies. Ann Trop Med Parasitol 1969;63:15-34.
- 4. Baldry DAT, Evison C. The distribution of Glossina morsitans in Zambia. 1983. In Proceedings of the Seventeenth Meeting, International Scientific Council for Trypanosomiasis Research and Control. Arusha, Tanzania: 391-397.
- 5. Fenn K, Matthews KR. The cell biology of Trypanosoma brucei differentiation. Curr Opin Microbiol 2007;10:539-546.
- 6. Hirumi H, Doyle JJ, Hirumi K. African Trypanosomes: Cultivation of animal-infective Trypanosoma brucei in-vitro. Science 1977;196:992-994.
- 7. Dillmann JS, Awan MA. The isolation of Trypanosoma brucei from Hippopotamus amphibius in the Luangwa Valley, Zambia. Trop Anim Health Prod 1972;4:135-137.
- 8. Awan MA. Identification by the blood incubation infectivity test of Trypanosoma brucei subspecies isolated from game animals in the Luangwa Valley, Zambia. Acta Trop 1979;36:343-347.
- 9. Dillmann JS, Townsend AJ. A trypanosomiasis survey of wild animals in the Luangwa Valley, Zambia. Acta Trop 1979;36:349-356.
- 10. Keymer IF. A survey of trypanosome infections in wild ungulates in the Luangwa valley, Zambia. Ann Trop Med Parasitol 1969;63:195-200.
- 11. Kinghorn A, York W. On the transmission of human trypanosomes by Glossina morsitans Westw. and on the occurence of human trypanosomes in game. Ann Trop Med Parasitol 1912;6:1-23.
- 12. Konnai S, Mekata H, Odbileg R, Simuunza M, Chembensof M, Witola WH, Tembo ME, Chitambo H, Inoue N, Onuma M, Ohashi K. Detection of Trypanosoma brucei in field-captured tsetse flies and identification of host species fed on by the infected flies. Vector Borne Zoonotic Dis 2008;8:565-573.
- 13. Mulla AF, Rickman LR. How do African game animals control trypanosome infections. Parasitol Today 1988;4:352-354.
Fig. 1
Trypanosoma brucei in greater kudu, Tragelaphus strepsiceros. The trypanosomes have pronounced free flagella and conspicuous undulating membranes. Giemsa stained blood slide, × 1,000 magnification.

Table 1.Wildlife species examined for the presence of hemoparasites, Trypanosoma brucei
Table 1.
|
Species of wildlife |
Total No. on game ranch (2005) |
No. sampled |
No. positives |
|
Greater kudu (Tragelaphus strepsiceros) |
25 |
6 |
4 |
|
Impala (Aepyceros melampus) |
509 |
38 |
- |
|
Waterbuck (Kobus ellipsiprymnus) |
63 |
8 |
- |
|
Bushbuck (Tragelaphus scriptus) |
57 |
4 |
- |
|
Warthog (Phacochoerus aethiopicus) |
205 |
8 |
- |
|
Puku (Kobus vardoni) |
252 |
14 |
- |
|
Kafue Lechwe (Kobus leche kafuensis) |
380 |
26 |
- |
|
Sable Antelope (Hippotragus niger) |
41 |
5 |
- |
|
Wildebeest (Connochaetes taurinus) |
60 |
8 |
- |
|
Zebra (Equus burchelli) |
80 |
12 |
- |
|
Tsessebe (Damaliscus lunatus) |
42 |
4 |
- |
|
Hartebeest (Alcephelus lichtensteini) |
60 |
7 |
- |
|
Reedbuck (Redunca redunca) |
72 |
6 |
- |
|
African buffallo (Syncerus caffer) |
15 |
15 |
- |
|
Total |
1,861 |
153 |
4 |
Citations
Citations to this article as recorded by

- GREATER KUDU (TRAGELAPHUS STREPSICEROS) MORTALITY IN EUROPEAN ZOOLOGICAL INSTITUTIONS: A RETROSPECTIVE STUDY
Antoine Leclerc, Benjamin Lamglait, Thierry Petit, Yannick Roman, Joerg Jebram
Journal of Zoo and Wildlife Medicine.2016; 47(2): 531. CrossRef - Occurrence of haemoparasites in cattle in Monduli district, northern Tanzania
Isihaka J. Haji, Imna Malele, Boniface Namangala
Onderstepoort J Vet Res.2014;[Epub] CrossRef - Detection of Parasites and Parasitic Infections of Free-Ranging Wildlife on a Game Ranch in Zambia: A Challenge for Disease Control
Hetron Mweemba Munang'andu, Victor M. Siamudaala, Musso Munyeme, King Shimumbo Nalubamba
Journal of Parasitology Research.2012; 2012: 1. CrossRef